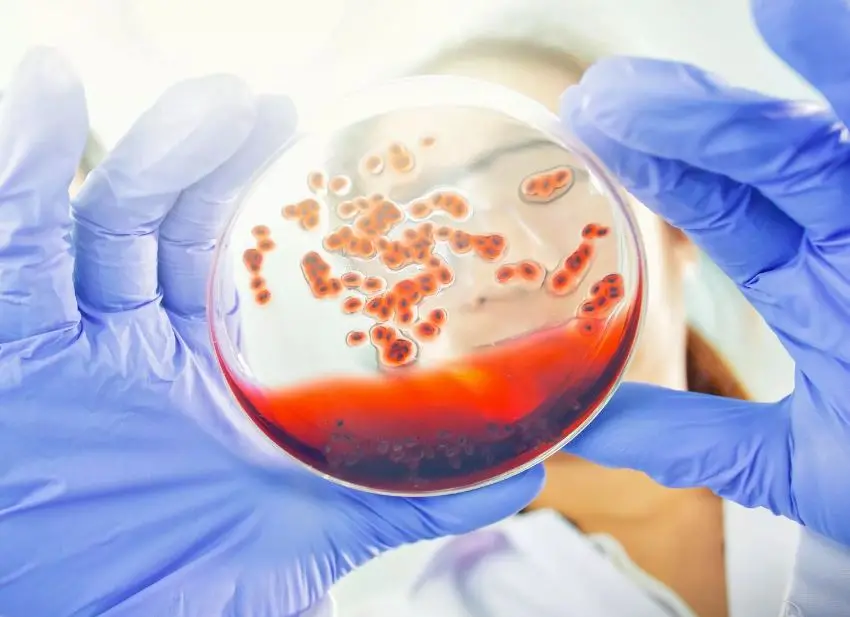

В РФ все большее распространение получают суперинфекции, это когда происходит заражение несколькими инфекциями одновременно. Об этом со ссылкой на медработников сообщило издание «Известия».
Врачи рассказали, что случаи, когда несколько вирусов циркулируют параллельно, происходят с завидной регулярностью, а в 2024 году к традиционным гриппу и ОРВИ добавились микоплазменная инфекция и коклюш.
По словам медиков, наиболее частые сочетания: грипп А и риновирус, грипп А и аденовирус, парагрипп второго типа и аденовирус, риновирус и аденовирус. Встречаются случаи и тройной инфекции: грипп А, риновирус и аденовирус.
Специалисты предупредили, что сочетание вирусов ведет к более тяжелому течению заболевания и может привести с дополнительным осложнениям.
Причин этого медики перечислили несколько: в настоящее время проходит пик заболеваемости, так как вирусы быстрее распространяются зимой и более устойчивы при низкой температуре. А снижение влажности в помещениях приводит к сухости слизистых оболочек, что делает организм более уязвимым перед инфекциями.
Ранее портал ГИПОРТ сообщал, что в Роспотребнадзоре посоветовали привиться от менингококковой инфекции.

И что теперь делать, как предохраняться?